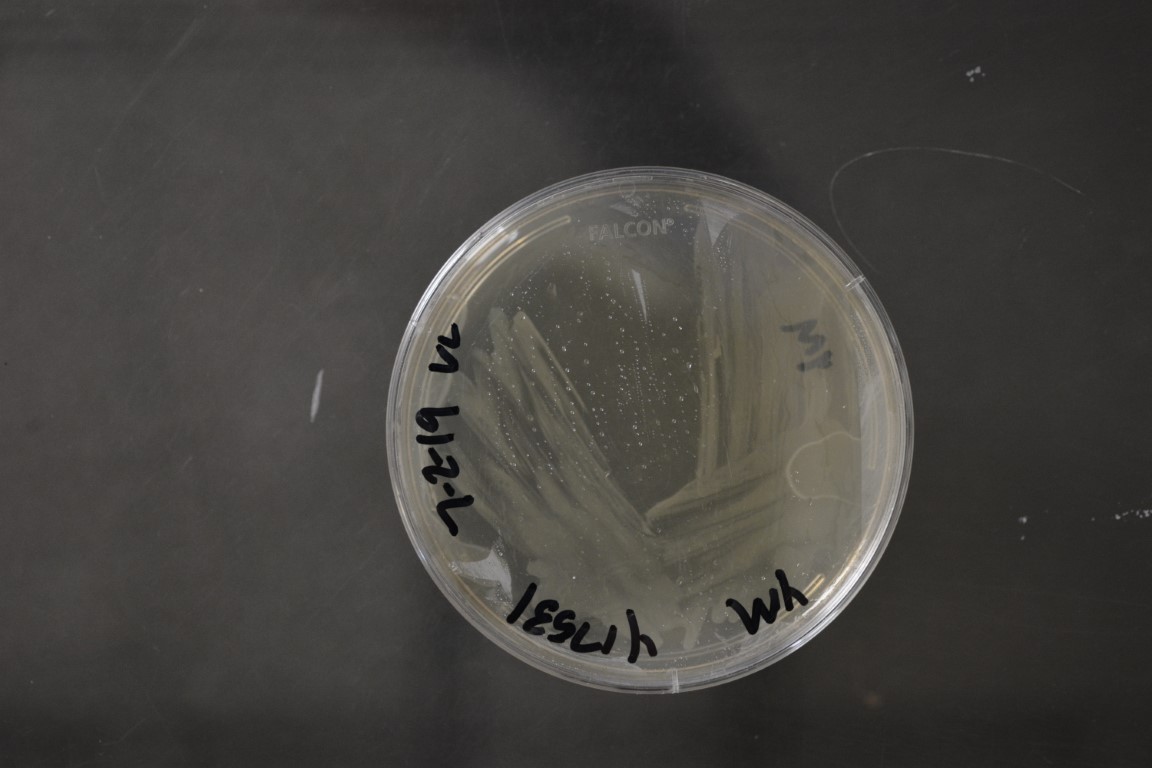

Kloeckera lindneri
NRRL Y-17531(Type Strain)
Accession numbers in other collections:CBS 285=CCRC 21446
Source:T.Boekhout CBS,Delft,The Netherlands
Isolated from(substrate):SL,soil
Substrate location:Java,Indonesia
Genetic info:Boekhout PCR,Robnett PCR#791,#A463-special.GenBank:D1/D2(U84226),ITS(AJ512430),ACTIN(AM039454).
Growth media:Yeast Extract-Malt Extract-Peptone-Glucose(YM for yeasts)(number 6)
Optimum growth temperature:25C
Strain images:
NRRL_Y-17531_6.JPG

Comments:type strain of Pseudosaccharomyces lindneri